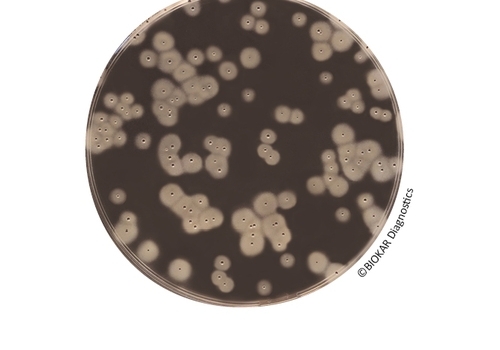

Staphylococcus

Baird-Parker Agar With Egg Yolk Tellurite
Baird-Parker Agar With Egg Yolk Tellurite Baird-Parker Agar with egg yolk and potassium..
More
Baird Parker RPF Agar
Baird Parker RPF Agar Baird Parker RPF (RPF = Rabbit Plasma Fibrinogen) Agar is used for the..
More
Brain-Heart Broth
Brain-Heart Broth Brain-Heart Broth is a buffered nutrient medium used for the culture of a wide..
More
Buttiaux-Brogniart Hypersalted Broth (DOUBLE CONCENTRATION)
Buttiaux-Brogniart Hypersalted Broth (DOUBLE CONCENTRATION) Buttiaux-Brogniart Hypersalted Broth..
More
COAGULASE Rabbit Plasma
COAGULASE Rabbit Plasma Rabbit Plasma recovered over EDTA and freeze-dried is used for the..
More
EASY STAPH Agar
EASY STAPH Agar EASY STAPH is an alternative method for the enumeration of coagulase positive..
More
Giolitti And Cantoni Broth With Tween 80 (BASE)
Giolitti And Cantoni Broth With Tween 80 (BASE) Giolitti and Cantoni Broth with Tween 80 is a..
More
Mannitol Salt Agar
Mannitol Salt Agar Mannitol Salt agar is used for the selective isolation, detection and..
More